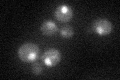
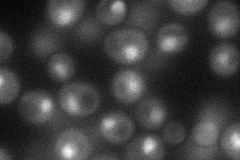
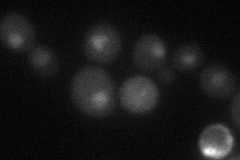

View description
Subunit of the SWI/SNF chromatin remodeling complex involved in transcriptional regulation; functions interdependently in transcriptional activation with Snf2p and Snf5p
Localization:
Intensity:
Fold change:
Significance:
-
C’ GFP library in SD
nucleus28.94 -
N' NOP1pr-GFP in SD
cytosol,nucleus50.3899 -
N' TEF2pr-mCherry in SD
punctate19.6754 -
N' NATIVEpr-GFP in SD

nucleus37.938 -
N' TEF2pr-VC and Cyto-VN in SD

#N/A0 -
C’ GFP library in SD+DTT

nucleus23.820.82No -
C’ GFP library in SD+H2O2

nucleus29.591.02No -
C’ GFP library in Starvation Media

nucleus28.830.99No -
C’ GFP library on the background of Pup2-DaMP

nucleus -
C’ GFP library on the background of CCT mutant

nucleus25.94180.896019No
